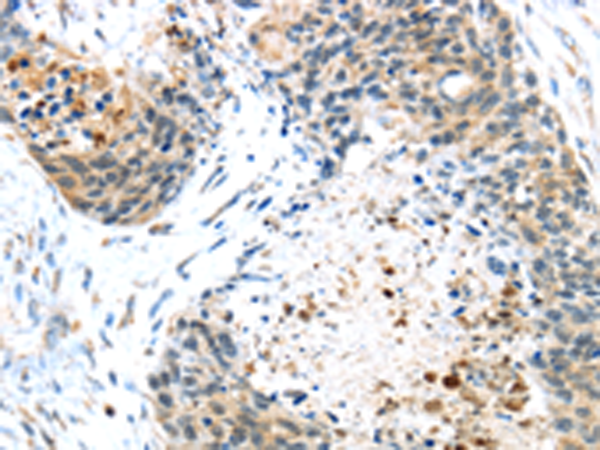

-
分类: 科研抗体货号: P02100别名:应用: WB,IHC反应种属: Human, Mouse
-
分类: 科研抗体货号: P02020别名: Ipi3; R32184_1应用: WB,IHC反应种属: Human, Mouse
-
分类: 科研抗体货号: P01920别名: HAT应用: WB,IHC反应种属: Human, Rat
-
分类: 科研抗体货号: P02094别名: EMC5; TMEM32应用: WB,IHC反应种属: Human, Mouse, Rat
-
分类: 科研抗体货号: P01915别名: CAPH2; MT-SP2; TMPRSS3应用: WB,IHC反应种属: Human, Mouse
-
分类: 科研抗体货号: P02005别名:应用: WB,IHC反应种属: Human, Mouse, Rat
-
分类: 科研抗体货号: P02092别名: NAAGS; FAM80B; NAAGS-I应用: IHC反应种属: Human, Mouse
-
分类: 科研抗体货号: P02085别名: ECO; ICK; MRK; LCK2; EJM10应用: IHC反应种属: Human, Mouse, Rat
-
分类: 科研抗体货号: P02071别名: Dlc2; DNCL1B; RSPH22应用: WB反应种属: Human, Mouse, Rat
-
分类: 科研抗体货号: P02002别名:应用: WB,IHC反应种属: Human, Mouse

鄂公网安备42018502007531号
鄂公网安备42018502007531号

